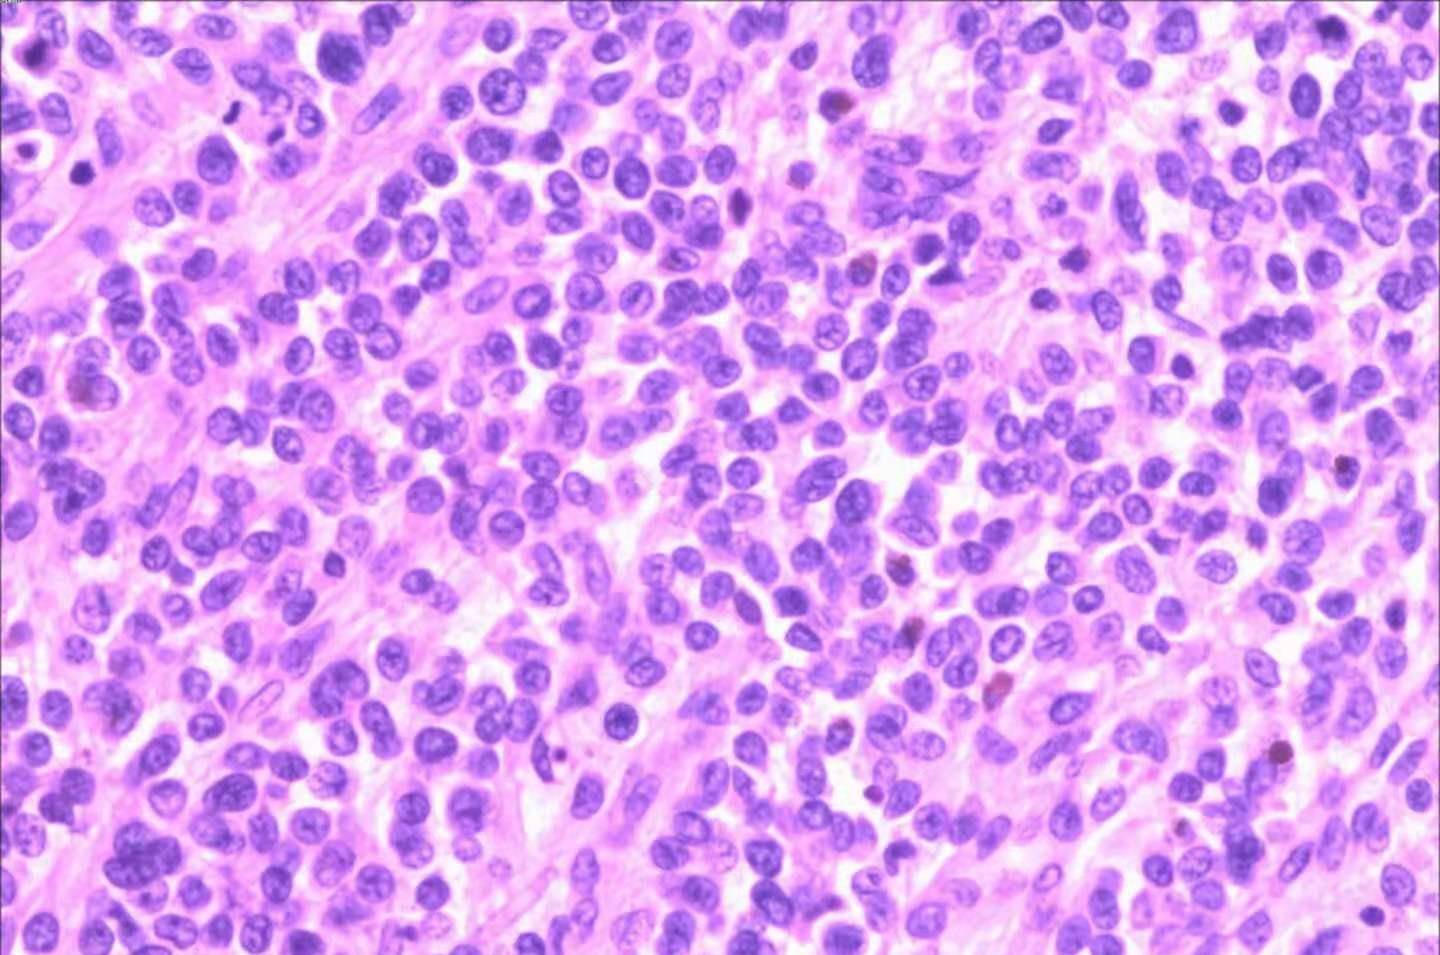
诊治|限制性心肌病，心肌病中最罕见的类型，其诊治手段有哪些呢？

诊治|限制性心肌病,心肌病中最罕见的类型,其诊治手段有哪些呢?
导语:限制性心肌病分为:非闭塞型(心肌被某种异常物质所浸润)和闭塞型(心内膜和心内膜下纤维化) 。 每种类型都可以是弥漫性或者非弥漫性的(当病变仅累及单心室或是不均匀地影响单心室的某一部分) 。 限制性心肌病(RCM)以心室壁顺应性下降 , 舒张期充盈受阻为特点;单心室(最常见左心室受累)或双心室均可能受到影响 。 症状包括乏力和劳力性呼吸困难 。 根据超声心动图或心导管检查诊断 。 治疗通常不够满意 , 最好是针对病因治疗 , 外科手术有时有用 。

文章图片
一、限制性心肌病的病因目前还不明确 , 但一些临床研究已经发现 , 它可能与系统性或遗传性疾病有关
1、病因
【诊治|限制性心肌病,心肌病中最罕见的类型,其诊治手段有哪些呢?】限制性心肌病并不总是原发性心脏疾病 , 虽然病因尚不清楚 , 但它可能是由系统性或遗传性疾病引起的;已确定的病因有限制性心肌病的病因.有些疾病在引起限制性心肌病的同时也影响到其他组织(如淀粉样变、血色病) 。 淀粉样蛋白(淀粉样变性疾病)或是铁(血色素沉着症)除在心肌内浸润外往往也可影响到其他器官 , 但很少累及冠状动脉 。 但淀粉样变很少累及冠状动脉 。
结节病结节病和Fabry病也可影响房室结传导组织 。 洛夫勒综合征L?ffler综合征(主要累及心脏的嗜酸细胞增多征的一个亚型)发生在热带 , 开始时以嗜酸细胞增多性急性动脉炎起病 , 随后在心内膜 , 腱索及房室瓣上形成血栓 , 并进一步进展为纤维化 。 心内膜弹力纤维增生症(EFE)发生在温带地区 , 仅累及左心室 。
2、病理生理
心内膜增厚或者心肌浸润(有时伴有心肌细胞坏死 , 乳头肌浸润 , 代偿性心肌肥厚和纤维化)可发生在单心室(典型的是左室)或者双心室 。 由此可致二尖瓣或三尖瓣功能障碍而引起反流 。 功能性的房室瓣反流可能是由于心肌浸润或是心内膜增厚所致 。
文章图片
二、确诊限制性心肌病需要做哪些检查呢?以下6种手段 , 可以帮助确诊限制性心肌病
1、症状诊断
心力衰竭和保留射血分数的患者应考虑限制性心肌病 , 特别是已诊断出有已知可导致限制性心肌病的全身性疾病时 。 然而 , 潜在的疾病可能表现并不明显 。
2、心电图
心电图可表现为ST段和T波异常 , 可有低电压 , 通常没有特异性 。 有时会出现非既往心肌梗塞所致的病理性Q波 。 由于代偿性心肌肥大或传导异常(包括房室传导阻滞)导致的左心室肥厚有时会发生 。

文章图片
3、X线检查
胸部X线检查 , 心脏大小通常正常或较小 , 但晚期淀粉样变性或血色素沉着症患者 , 心脏可增大 。
4、超声心动图
超声心动图检查超声心动图示左室收缩功能正常 。 常见的发现包括心房扩大以及心肌肥厚 。 组织多普勒成像通常提示LV充盈压升高 , 尽管射血分数正常 , 但应变成像可显示纵向收缩受损 。 其他常见的表现包括心房扩大和心肌肥厚 。 在淀粉样变中 , 可观察到心肌有非常亮的强回声 。
5、MRI
如果仍不能确诊 , MRI可以显示出心肌浸润性疾病(例如被淀粉样蛋白或是铁浸润)所致的心肌结构异常 。 MRI以及心脏CT可以检测心包增厚 , 有助于诊断临床表现类似RCM的心包缩窄 。
- 西海岸|山东1地发现1例入境确诊治愈后复阳人员
- 刘镇|山东1地发现1例入境确诊治愈后复阳人员
- 疫情|青岛发现1例入境确诊治愈后复阳人员 珠海阳性病例增至7例,初筛为奥密克戎病毒
- 异位囊肿|《第三版子宫内膜异位症的诊治指南》发布
- 眼病|“十四五”眼健康规划发布,眼底病诊治及长期管理成新增重点
- 中医肿瘤研究院|成都中医肿瘤研究院万年路2号:中医抗癌消瘤体系为什么要个性化诊治肿瘤?
- 体重|成都中医肿瘤研究院万年路2号:联袂华西医院退休专家诊治肿瘤体重下降
- 为进一步提升呼吸专科疾病诊治水平|广汉市人民医院PCCM规范化建设项目迎接国家专家组线上评审认定
- 临床医生|现代中医诊治新思维-麝香保心丸抗冠脉微循环障碍初探
- 中医肿瘤医院|成都中医肿瘤医院,成都中医肿瘤研究院:中医保守方案诊治卵巢癌,缓解患者症状
